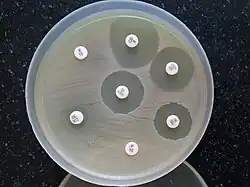

Clindamicina
Clindamicina | |
![]() | |
Nome IUPAC (sistemática) | |
| (2S,4R)-N-((1R)-2-chloro- 1-((3R,4R,5S,6R)-3,4,5-trihydroxy- 6-(methylthio)-tetrahydro-2H-pyran-2-yl)propyl)- 1-methyl-4-propylpyrrolidine-2-carboxamide | |
Identificadores | |
CAS |
18323-44-9 |
| J01FF01 | |
PubChem |
29029 |
| APRD00566 | |
Informação química | |
Fórmula molecular |
C18H33N2ClO5S |
Massa molar |
424.98 g/mol |
Farmacocinética | |
Biodisponibilidade |
90% (oral) 4–5% (tópico) |
| Hepático | |
| 2–3 horas | |
| Renal | |
Considerações terapêuticas | |
| Oral, IV, tópico, vaginal | |
Clindamicina é um antibiótico usado para o tratamento de uma série de infecções bacterianas, incluindo infecções ósseas ou articulares, doença inflamatória pélvica, faringite estreptocócica, pneumonia, otite média e endocardite.[1] Pode também ser usada no tratamento do acne[1][2] e de alguns casos de Staphylococcus aureus resistente à meticilina (MRSA).[3] Em associação com quinina, pode ser usada no tratamento de malária. Está disponível para administração por via oral, por injecção intravenosa e em pomada para aplicação na pele ou na vagina.[2]
Os efeitos adversos mais comuns incluem náuseas, diarreia, erupção cutânea e dor no local da injecção.[1] A clindamicina aumenta em cerca de quatro vezes o risco de contrair colite pseudomembranosa em ambiente hospitalar, pelo que só é recomendada quando outros antibióticos não são adequados.[4] Aparenta ser geralmente segura na gravidez. Pertence à classe das lincosamidas e atua no organismo bloqueando a produção de proteínas pelas bactérias.
A clindamicina foi produzida pela primeira vez em 1966 a partir da lincomicina.[5][6][7] Faz parte da Lista de Medicamentos Essenciais da Organização Mundial de Saúde[8] e está disponível como medicamento genérico.[9] Em 2017 foi o 137º medicamento mais receitado nos Estados Unidos, com mais de quatro milhões de receitas.[10][11]
Usos médicos
A clindamicina é usada principalmente para tratar infecções anaeróbias causadas por bactérias anaeróbias susceptíveis, incluindo infecções dentárias,[12] e infecções do trato respiratório, da pele, dos tecidos moles e peritonite.[13] Em pessoas com hipersensibilidade às penicilinas, a clindamicina também pode ser usada para tratar infecções causadas por bactérias aeróbias susceptíveis. Também é usada para tratar infecções ósseas e articulares, principalmente as causadas por staphylococcus aureus.[14] A aplicação tópica de fosfato de clindamicina pode ser usada para tratar acne leve a moderada.[15]
A partir de 18 de maio de 2021 a Associação Americana do Coração recomenda o uso da clindamicina como medicamento preventivo para cirurgias em pacientes cardiopatas com risco para endocardite e alérgicos a penicilina em locais onde haja o risco de septicemia(incluindo intervenções odontológicas). Antes de 28 de maio de 2021 o medicamento de escolha nesses casos era a claritromicina[16]
Acne

No tratamento da acne, a longo prazo o uso combinado de clindamicina tópica e peróxido de benzoílo apresenta resultados semelhantes ao uso combinado de ácido salicílico e peróxido de benzoílo. No entanto, a clindamicina tópica associada a peróxido de benzoílo é mais eficaz do que apenas clindamicina tópica.[17]
Bactérias susceptíveis
A clindamicina é mais eficaz contra infecções que envolvam os seguintes tipos de organismos:
- Cocos aeróbicos gram-positivos, incluindo alguns membros dos géneros Staphylococcus e Streptococcus (por exemplo pneumococo ), mas não enterococos.[18]
- Bactérias anaeróbias gram-negativas em forma de bastonete, incluindo alguns Bacteroides, Fusobacterium e Prevotella.[19]
A maioria das bactérias aeróbias gram-negativas (como Pseudomonas, Legionella, Haemophilus influenzae e Moraxella) são resistentes à clindamicina,[18][20] assim como as bactérias anaeróbias facultativas Enterobacteriaceae.[21] Uma excepção notável é a Capnocytophaga canimorsus, para a qual a clindamicina é o fármaco de eleição.[22]
A seguinte lista representa os dados de susceptibilidade de concentração inibitória mínima para alguns patogénicos clinicamente significativos:[23]
- Staphylococcus aureus: 0,016 μg/ml → 256 μg/ml
- Streptococcus pneumoniae: 0,002 μg/ml → 256 μg/ml
- Streptococcus pyogenes: <0,015 μg/ml → 64 μg/ml
Teste D
Ao testar uma cultura bacteriana gram-positiva quanto à sensibilidade à clindamicina, é comum realizar um "teste D" para determinar se há uma subpopulação de bactérias resistente a macrolídos presentes. Esse teste é necessário porque algumas bactérias expressam um fenótipo conhecido como MLSB, no qual os testes de sensibilidade indicam que as bactérias são susceptíveis à clindamicina, mas in vitro o patogénico apresenta resistência induzível.[24][25]
Para realizar um teste D, uma placa de ágar é inoculada com a bactéria em questão e dois discos impregnados com substâncias (um com eritromicina, um com clindamicina) são colocados entre 15 a 20 mm de distância na placa. Se a área de inibição ao redor do disco de clindamicina tiver a forma de "D", o resultado do teste é positivo e a clindamicina não deve ser usada devido à possibilidade de patogénicos resistentes e, por sua vez, falha da terapia. Se a área de inibição ao redor do disco de clindamicina for circular, o resultado do teste é negativo e a clindamicina pode ser usada.[26]
Malária
Administrada com cloroquina ou quinina, a clindamicina é eficaz e bem tolerada no tratamento da malária por Plasmodium falciparum; a última combinação é particularmente útil para crianças e é o tratamento de escolha para mulheres grávidas que estão infectadas em áreas onde a resistência à cloroquina é comum.[27][28] A clindamicina não deve ser usada como antimalárico por si só, embora pareça ser muito eficaz como tal, devido à sua acção lenta. Foi relatado que derivados isolados de Plasmodium falciparum da Amazónia peruana são resistentes à clindamicina, conforme evidenciado por testes de sensibilidade a drogas in vitro.[29]
Outros
A clindamicina pode ser útil em infecções de pele e tecidos moles causadas por Staphylococcus aureus resistente à meticilina (MRSA).[3] Muitas cepas de MRSA ainda são susceptíveis à clindamicina; entretanto, nos Estados Unidos, espalhando-se da costa oeste para o leste, o MRSA tem-se tornando cada vez mais resistente. Embora tenha sido usado em infecções intra-abdominais, esse uso geralmente não é recomendado devido à resistência.[1]
A clindamicina é usada em casos de suspeita de síndrome do choque tóxico,[30] frequentemente em combinação com um agente bactericida como a vancomicina. A justificativa para essa abordagem é uma suposta sinergia entre a vancomicina, que causa a morte da bactéria por quebra da parede celular, e a clindamicina, que é um poderoso inibidor da síntese de toxinas. Os estudos in vitro e in vivo mostraram que a clindamicina reduz a produção de exotoxinas pelos estafilococos;[31] também pode induzir alterações na estrutura da superfície das bactérias que as tornam mais sensíveis ao ataque do sistema imunológico (opsonização e fagocitose).[32][33]
Foi comprovado que a clindamicina diminui o risco de partos prematuros em mulheres com diagnóstico de vaginose bacteriana durante o início da gravidez para cerca de um terço do risco de mulheres não tratadas.[34] A combinação de clindamicina e quinina é o tratamento padrão para babesiose grave.[35] A clindamicina também pode ser usada para tratar a toxoplasmose[18][36][37] e, em combinação com a primaquina, é eficaz no tratamento da pneumonia por Pneumocystis jirovecii leve a moderada.[38] A clindamicina, aplicada na pele ou por via oral, também pode ser usada na hidrosadenite supurativa.[39]
Efeitos secundários
Reacções adversas comuns a medicamentos associadas à terapia sistémica com clindamicina – encontrado em mais de 1% das pessoas – incluem: diarreia, colite, náuseas, vómitos, dor abdominal ou cólicas e/ou erupção cutânea. Doses altas (intravenosas e orais) podem causar disgeusia. Reacções adversas comuns a medicamentos associadas a formulações tópicas – encontradas em mais de 10% das pessoas – incluem: secura, queimaduras, prurido, escamação ou descamação da pele, eritema e oleosidade. Os efeitos colaterais adicionais incluem dermatite de contacto.[40][41] Efeitos colaterais comuns – encontrados em mais de 10% das pessoas – em aplicações vaginais incluem infecção fúngica. Raramente – em menos de 0,1% das pessoas – a terapia com clindamicina foi associada a anafilaxia, discrasias sanguíneas, poliartrite, icterícia, níveis elevados de enzimas hepáticas, disfunção renal, paragem cardíaca e/ou hepatotoxicidade.[40]
Clostridioides difficile
A colite é uma condição potencialmente letal frequentemente associada à clindamicina, mas que também ocorre com outros antibióticos.[4][42] O crescimento excessivo de clostridioides difficile, que é inerentemente resistente à clindamicina, resulta na produção de uma toxina que causa uma série de efeitos secundários, desde diarreia até colite e megacólon tóxico.[40][43]
Gravidez e amamentação
O uso de clindamicina durante a gravidez é geralmente considerado seguro.[44]
A clindamicina é classificada como compatível com a amamentação pela Academia Americana de Pediatria,[45] no entanto, a OMS categoriza-a como "evitar, se possível".[46] É classificado como "L2" provavelmente compatível com a amamentação, segundo Medicamentos e Leite Materno.[47] Uma revisão de 2009 concluiu que era provavelmente seguro em mães que amamentam, mas encontrou uma complicação (hematoquezia) num bebé amamentado que pode ser atribuída à clindamicina.[48] LactMed lista efeitos gastrointestinais potencialmente negativos em bebés cujas mães o tomam durante a amamentação, mas não viu isso como justificativa para interromper a amamentação.[49]
Interacções
A clindamicina pode prolongar os efeitos de drogas bloqueadoras neuromusculares, como a succinilcolina e o vecurónio.[50][51][52] A sua semelhança com o mecanismo de acção dos macrolídos e do cloranfenicol significa que não devem ser administrados simultaneamente, pois isso causa incompatibilidade[20] e uma possível resistência cruzada in vitro.[53]
Química

A clindamicina é um derivado semissintético da lincomicina, um antibiótico natural produzido pela actinobacteria streptomyces lincolnensis. É obtido por 7 (S) - cloro - substituição do grupo 7 (R) - hidroxila da lincomicina.[55][56] A síntese da clindamicina foi anunciada pela primeira vez por BJ Magerlein, RD Birkenmeyer e F Kagan na quinta Conferência Interciência sobre Agentes Antimicrobianos e Quimioterapia (ICAAC) em 1966.[57] Está no mercado desde 1968.[41]
A clindamicina é branca ou amarela. É muito solúvel em água.[58] O fosfato de clindamicina usado topicamente é um pró-fármaco fosfato-éster da clindamicina.[54]
Mecanismo de ação

A clindamicina tem um efeito principalmente bacteriostático. Em concentrações mais altas, pode ser bactericida.[58] É um inibidor da síntese de proteína bacteriana por inibir a translocação ribossomal,[59] de uma forma semelhante aos macrolídos. Ela faz isso ligando-se ao rRNA 50S da grande subunidade do ribossoma bacteriano, sobrepondo-se aos locais de ligação da 2-oxazolidona, pleuromutilina e antibióticos macrolídos, entre outros.[18][60] A ligação é reversível.[61] A clindamicina é mais eficaz do que a lincomicina.[58]
As estruturas cristalinas de raios-X da clindamicina ligada aos ribossomos (ou subunidades ribossómicas) derivadas de escherichia coli,[62] deinococcus radiodurans[63] e Haloarcura marismortui[64] foram determinadas; a estrutura do antibiótico, intimamente relacionada, da lincomicina ligada à subunidade ribossómica 50S de staphylococcus aureus também foi relatada.[65]
Mercado
Custo
A clindamicina está disponível como medicamento genérico e não é muito cara.[9][66] O custo bruto no mundo em desenvolvimento é de cerca de 0,06 a 0,12 dólares por comprimido.[67] Nos Estados Unidos, custa cerca de 2,70 dólares por dose.[1]
Formulários disponíveis
As preparações de clindamicina que são administradas por via oral incluem cápsulas (contendo cloridrato de clindamicina) e suspensões orais (contendo cloridrato de palmitato de clindamicina).[27] A suspensão oral não é recomendada para administração de clindamicina em crianças, devido ao seu sabor e odor extremamente desagradáveis. A clindamicina é formulada num creme vaginal e como supositórios vaginais para o tratamento da vaginose bacteriana.[34] Também está disponível para administração tópica na forma de gel, loção e espuma (cada um contendo fosfato de clindamicina) e uma solução em etanol (contendo cloridrato de clindamicina) e é usado principalmente como um tratamento prescrito para acne.[68]
Vários tratamentos combinados de acne contendo clindamicina também são comercializados, como formulações de produto-único de clindamicina com peróxido de benzoílo - vendido como BenzaClin (Sanofi-Aventis), Duac (uma forma de gel feita pela Stiefel) e Acanya, entre outros nomes comerciais - e, nos Estados Unidos, uma combinação de clindamicina e tretinoína, vendida como Ziana.[69] Na Índia, supositórios vaginais contendo clindamicina em combinação com clotrimazol são fabricados pela Olive Health Care e vendidos como Clinsup-V.[70] No Egito, um creme vaginal contendo clindamicina é vendido com o nome Vagiclind, sendo indicado para vaginose.[71][72]
A clindamicina está disponível como medicamento genérico, tanto para uso sistémico (oral e intravenoso) quanto tópico.[27] A excepção é o supositório vaginal, que não está disponível como genérico nos EUA.[73] A clindamicina é comercializada como genérica e sob nomes comerciais, incluindo Cleocin HCl, Cleocin Pediatric, Cleocin Phosphate, Cleocin Phosphate ADD-Vantage, Clindesse e ClindaMax Vaginal.[74]
Uso veterinário
Os usos veterinários da clindamicina são bastante semelhantes às suas indicações em humanos e incluem o tratamento de osteomielite,[75] infecções de pele e toxoplasmose, para as quais é o medicamento de eleição em cães e gatos.[76] O seu uso pode ser feito por via oral e topicamente.[58] Uma desvantagem é que a resistência bacteriana pode desenvolver-se rapidamente.[58] Também podem ocorrer distúrbios gastrointestinais.[58] A toxoplasmose raramente causa sintomas na maioria dos gatos adultos, ocorrendo mais frequentemente em filhotes ou em gatos com imunocomprometidos.[77]
Notas
- Este artigo foi parcialmente traduzido do artigo da Wikipedia em inglês, cujo título é «Clindamycin».
Referências
- 1 2 3 4 5 «Clindamycin Hydrochloride». The American Society of Health-System Pharmacists. Consultado em 4 de setembro de 2015. Cópia arquivada em 5 de setembro de 2015
- 1 2 Hidradenitis suppurativa. Berlin: Springer; 2006. ISBN 9783540331018. p. 152.
- 1 2 «Clinical practice. Skin and soft-tissue infections caused by methicillin-resistant Staphylococcus aureus». N. Engl. J. Med. 357: 380–90. Julho de 2007. PMID 17652653. doi:10.1056/NEJMcp070747
- 1 2 «Antibiotics and hospital-acquired Clostridium difficile-associated diarrhoea: a systematic review» (PDF). J Antimicrob Chemother. 51: 1339–50. 2003. PMID 12746372. doi:10.1093/jac/dkg254. Cópia arquivada (PDF) em 7 de janeiro de 2016
- ↑ 9. PMID 22346533.
- ↑ Neonatal Formulary: Drug Use in Pregnancy and the First Year of Life. John Wiley & Sons 7 ed. [S.l.: s.n.] 2014. ISBN 9781118819517
- ↑ 9. PMID 22346533.
- ↑ World Health Organization model list of essential medicines: 21st list 2019. World Health Organization. Geneva: [s.n.] 2019. WHO/MVP/EMP/IAU/2019.06. License: CC BY-NC-SA 3.0 IGO
- 1 2 Tarascon Pocket Pharmacopoeia 2015 Deluxe Lab-Coat Edition. Jones & Bartlett Learning; 2015. ISBN 9781284057560. p. 108.
- ↑ «The Top 300 of 2020». ClinCalc. Consultado em 11 de abril de 2020
- ↑ «Clindamycin - Drug Usage Statistics». ClinCalc. Consultado em 11 de abril de 2020
- ↑ «Clindamycin in dentistry: more than just effective prophylaxis for endocarditis?». Oral Surg Oral Med Oral Pathol Oral Radiol Endod. 100: 550–8. Novembro de 2005. PMID 16243239. doi:10.1016/j.tripleo.2005.02.086
- ↑ «Cleocin I.V. Indications & Dosage». RxList.com. 2007. Consultado em 1 de dezembro de 2007. Cópia arquivada em 27 de novembro de 2007
- ↑ «Antibiotic treatment of gram-positive bone and joint infections» (PDF). J Antimicrob Chemother. 53: 928–35. 2004. PMID 15117932. doi:10.1093/jac/dkh191. Cópia arquivada (PDF) em 6 de novembro de 2015
- ↑ «Diagnosis and treatment of acne» (PDF). Am Fam Physician. 69: 2123–30. Maio de 2004. PMID 15152959. Cópia arquivada (PDF) em 27 de julho de 2011
- ↑ «Prevention of Viridans Group Streptococcal Infective Endocarditis». AHA SCIENTIFIC STATEMENT. Cópia arquivada em 8 de novembro de 2021
- ↑ «Meta-analysis comparing efficacy of benzoyl peroxide, clindamycin, benzoyl peroxide with salicylic acid, and combination benzoyl peroxide/clindamycin in acne». J. Am. Acad. Dermatol. 63: 52–62. Julho de 2010. PMID 20488582. doi:10.1016/j.jaad.2009.07.052
- 1 2 3 4 «Lincosamides, Oxazolidinones, and Streptogramins». Merck Manual of Diagnosis and Therapy. Merck & Co. Novembro de 2005. Consultado em 1 de dezembro de 2007. Cópia arquivada em 2 de dezembro de 2007
- ↑ «Clindamycin: Uses, Dosage, Side Effects, Warning & Interactions». RxList (em inglês). Consultado em 23 de novembro de 2020
- 1 2 Bell EA (janeiro de 2005). «Clindamycin: new look at an old drug». Infectious Diseases in Children. Consultado em 1 de dezembro de 2007. Cópia arquivada em 8 de outubro de 2011
- ↑ «Clindamycin - an overview | ScienceDirect Topics». www.sciencedirect.com. Consultado em 23 de novembro de 2020
- ↑ «Antimicrobial treatment of Capnocytophaga infections». Int J Antimicrob Agents. 29: 367–73. Abril de 2007. PMID 17250994. doi:10.1016/j.ijantimicag.2006.10.005
- ↑ Clindamycin Phosphate Susceptibility and Minimum Inhibitory Concentration (MIC) Data, PDF de 1 de junho de 2020
- ↑ Perez, Leandro Reus Rodrigues; Caierão, Juliana; Antunes, Ana Lúcia Souza; d'Azevedo, Pedro Alves (abril de 2007). «Use of the D test method to detect inducible clindamycin resistance in coagulase negative staphylococci (CoNS)». Brazilian Journal of Infectious Diseases (em inglês) (2): 186–188. ISSN 1413-8670. doi:10.1590/S1413-86702007000200002. Consultado em 23 de novembro de 2020
- ↑ «the_d_test [TUSOM | Pharmwiki]». tmedweb.tulane.edu. Consultado em 23 de novembro de 2020
- ↑ Macrolide-Inducible Resistance to Clindamycin and the D-Test.
- 1 2 3 «Clindamycin as an Antimalarial Drug: Review of Clinical Trials» (PDF). Antimicrobial Agents and Chemotherapy. 46: 2315–20. 2002. ISSN 0066-4804. PMC 127356
. PMID 12121898. doi:10.1128/AAC.46.8.2315-2320.2002. Cópia arquivada (PDF) em 29 de setembro de 2011 - ↑ «Treatment of malaria in the United States: a systematic review». JAMA. 297: 2264–77. 2007. PMID 17519416. doi:10.1001/jama.297.20.2264
- ↑ «Genome scanning of Amazonian Plasmodium falciparum shows subtelomeric instability and clindamycin-resistant parasites». Genome Research. 20: 1534–44. 2010. PMC 2963817
. PMID 20829224. doi:10.1101/gr.105163.110 - ↑ «Managing toxic shock syndrome with antibiotics». Expert Opin Pharmacother. 5: 1701–10. 2004. PMID 15264985. doi:10.1517/14656566.5.8.1701
- ↑ Coyle EA, Society of Infectious Diseases Pharmacists (2003). «Targeting bacterial virulence: the role of protein synthesis inhibitors in severe infections. Insights from the Society of Infectious Diseases Pharmacists». Pharmacotherapy. 23: 638–42. PMID 12741438. doi:10.1592/phco.23.5.638.32191. Cópia arquivada em 5 de dezembro de 2008
- ↑ «Regulation of protein A biosynthesis in Staphylococcus aureus by certain antibiotics: its effect on phagocytosis by leukocytes». J Antimicrob Chemother. 12: 587–97. 1983. PMID 6662837. doi:10.1093/jac/12.6.587
- ↑ «Potentiation of opsonization and phagocytosis of Streptococcus pyogenes following growth in the presence of clindamycin». Journal of Clinical Investigation. 67: 1249–56. Maio de 1981. PMC 370690
. PMID 7014632. doi:10.1172/JCI110152 - 1 2 Lamont RF (2005). «Can antibiotics prevent preterm birth—the pro and con debate». BJOG. 112: 67–73. PMID 15715599. doi:10.1111/j.1471-0528.2005.00589.x
- ↑ «Babesiosis» (PDF). Clin Microbiol Rev. 13: 451–69. Julho de 2000. PMC 88943
. PMID 10885987. doi:10.1128/CMR.13.3.451-469.2000. Cópia arquivada (PDF) em 21 de julho de 2006 - ↑ «Okuläre Toxoplasmose» [Ocular toxoplasmosis]. Ophthalmologe (em alemão). 104: 603–16. 2007. PMID 17530262. doi:10.1007/s00347-007-1535-8
- ↑ «Intérêt de la clindamycine dans le traitement de la toxoplasmose oculaire» [Value of clindamycin in the treatment of ocular toxoplasmosis]. Journal Français d'Ophtalmologie (em francês). 20: 418–22. 1997. ISSN 0181-5512. PMID 9296037
- ↑ Fishman JA (junho de 1998). «Treatment of Infection Due to Pneumocystis carinii» (PDF). Antimicrobial Agents and Chemotherapy. 42: 1309–14. ISSN 0066-4804. PMC 105593
. PMID 9624465. doi:10.1128/AAC.42.6.1309. Cópia arquivada (PDF) em 7 de janeiro de 2016 - ↑ Saunte, Ditte Marie Lindhardt; Jemec, Gregor Borut Ernst (28 de novembro de 2017). «Hidradenitis Suppurativa: Advances in Diagnosis and Treatment». JAMA (em inglês). 318: 2019–2032. ISSN 0098-7484. PMID 29183082. doi:10.1001/jama.2017.16691
- 1 2 3 Rossi S, editor. Australian Medicines Handbook 2006. Adelaide: Australian Medicines Handbook; 2006.
- 1 2 Clindamycin and taste disorders. 2007;64(4):542–545. doi:10.1111/j.1365-2125.2007.02908.x. PMID 17635503.
- ↑ Starr J (2005). «Clostridium difficile associated diarrhoea: diagnosis and treatment». BMJ. 331: 498–501. PMC 1199032
. PMID 16141157. doi:10.1136/bmj.331.7515.498 - ↑ 330. PMID 8043060.
- ↑ 46. PMID 12121898.
- ↑ «Transfer of drugs and other chemicals into human milk». Pediatrics. 108: 776–89. Setembro de 2001. PMID 11533352. doi:10.1542/peds.108.3.776
- ↑ «Breastfeeding and maternal medication : recommendations for drugs in the Eleventh WHO Model List of Essential Drugs». World Health Organization. 2002
- ↑ Medications & mothers' milk. New York, NY: Springer; 2017. ISBN 9780826128584. OCLC 959873270.
- ↑ 29. PMID 19698015.
- ↑ «Clindamycin». National Library of Medicine (US). Drugs and Lactation Database (LactMed). 2006. PMID 30000267. Bookshelf ID: NBK501208. Consultado em 13 de novembro de 2019
- ↑ «Prolongation of a pancuronium-induced neuromuscular blockade by clindamycin». Anesthesiology. 41: 407–8. 1974. PMID 4415332. doi:10.1097/00000542-197410000-00023
- ↑ «Clindamycin-induced neuromuscular blockade». Can J Anaesth. 42: 614–7. 1995. PMID 7553999. doi:10.1007/BF03011880
- ↑ «Prolongation of rapacuronium neuromuscular blockade by clindamycin and magnesium» (PDF). Anesth Analg. 94: 123–4, table of contents. 2002. PMID 11772813. doi:10.1097/00000539-200201000-00023
- ↑ «Clindamycin - an overview | ScienceDirect Topics». www.sciencedirect.com. Consultado em 23 de novembro de 2020
- 1 2 «Clindamycin Phosphate Topical Solution». RxList. Consultado em 27 de janeiro de 2017. Cópia arquivada em 2 de fevereiro de 2017
- ↑ 13. PMID 4916317.
- ↑ «Microbiological and Pharmacological Behavior of 7-Chlorolincomycin». Appl Microbiol. 17: 653–7. 1969. PMC 377774
. PMID 4389137. doi:10.1128/AEM.17.5.653-657.1969 - ↑ 6. PMID 5985307.
- 1 2 3 4 5 6 64. PMID 14762701.
- ↑ Clindamycin University of Michigan. Consultado em 31 de julho de 2009
- ↑ Ribosome-targeting antibiotics and mechanisms of bacterial resistance. 12. PMID 24336183.
- ↑ Beauduy CE, Winston LG. Tetracyclines, Macrolides, Clindamycin, Chloramphenicol, Streptogramins, & Oxazolidinones. In: Katzung BG. eds. Basic & Clinical Pharmacology, 14e New York, NY: McGraw-Hill; .
- ↑ 107. PMID 20876128.
- ↑ Structural basis for the interaction of antibiotics with the peptidyl transferase centre in eubacteria. 2001;413(6858):814–821. doi:10.1038/35101544. PMID 11677599.
- ↑ Structures of MLSBK Antibiotics Bound to Mutated Large Ribosomal Subunits Provide a Structural Explanation for Resistance. 2005;121(2):257–270. doi:10.1016/j.cell.2005.02.005. PMID 15851032.
- ↑ Structural insights of lincosamides targeting the ribosome of Staphylococcus aureus. 2017;45(17):10284–10292. doi:10.1093/nar/gkx658. PMID 28973455.
- ↑ Cunha, Burke A.; Cunha, Burke (2009). Infectious Diseases in Critical Care Medicine. CRC Press (em inglês). [S.l.: s.n.] ISBN 978-1-4200-9241-7
- ↑ «Clindamycin». International Drug Price Indicator Guide. Consultado em 6 de setembro de 2015. Cópia arquivada em 7 de janeiro de 2016
- ↑ «A randomized, double-blind comparison of a clindamycin phosphate/benzoyl peroxide gel formulation and a matching clindamycin gel with respect to microbiologic activity and clinical efficacy in the topical treatment of acne vulgaris». Clin Ther. 24: 1117–33. 2002. PMID 12182256. doi:10.1016/S0149-2918(02)80023-6
- ↑ FDA Approvals: Ziana, Kadian, Polyphenon E; December 1, 2006.
- ↑ «CLINSUP V SUPPOSITARY ( RESILIENT COSMECEUTICALS PVT LTD ) - Buy CLINSUP V SUPPOSITARY Online at best Price in India - MedPlusMart». www.medplusmart.com (em inglês). Consultado em 23 de novembro de 2020
- ↑ «Vagiclind 2%». Drugs.com (em inglês). Consultado em 23 de novembro de 2020
- ↑ «Vagiclind 2% generic. Price of vagiclind 2%. Uses, Dosage, Side effects». ndrugs (em inglês). Consultado em 23 de novembro de 2020
- ↑ «Generic Cleocin Vaginal Availability». Drugs.com. Consultado em 13 de outubro de 2019
- ↑ «Clindamycin Uses, Dosage & Side Effects». Drugs.com (em inglês). Consultado em 23 de novembro de 2020
- ↑ (8 de fevereiro de 2005) "Osteomyelitis" Arquivado em 2008-01-07 no Wayback Machine, in Kahn, Cynthia M., Line, Scott, Aiello, Susan E. (ed.): The Merck Veterinary Manual, 9th ed., John Wiley & Sons. ISBN 0-911910-50-6. Consultado em 14 de dezembro de 2007.
- ↑ (8 de fevereiro de 2005) "Toxoplasmosis: Introduction" Arquivado em 2007-12-20 no Wayback Machine, in Kahn, Cynthia M., Line, Scott, Aiello, Susan E. (ed.): The Merck Veterinary Manual, 9th ed., John Wiley & Sons. ISBN 0-911910-50-6. Consultado em 14 de dezembro de 2007.
- ↑ «Toxoplasmosis». American Veterinary Medical Association (em inglês). Consultado em 23 de novembro de 2020
Ligações externas
- «Clindamycin». Drug Information Portal. U.S. National Library of Medicine
- «Clindamycin hydrochloride». Drug Information Portal. U.S. National Library of Medicine
